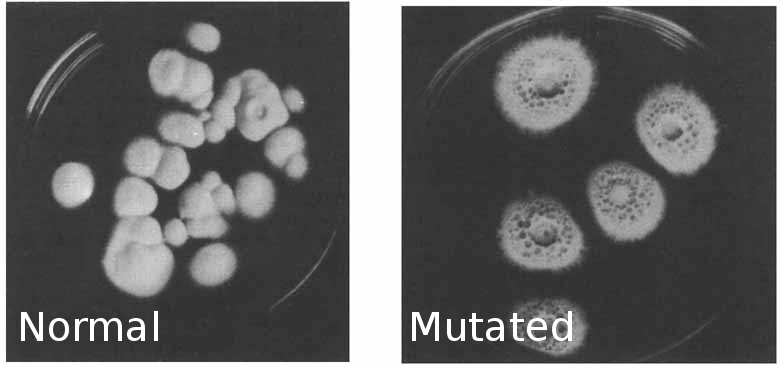

I thought I should make a thread about C. Paspali with some collected information. Seems like it would be just as good to post it in here.
Some real good information in the hyperlab posts on WD, needs better translation... This fungus is very promising because even without optimization, it can produce LSA at a density of around 1g pure LSA per gallon of liquid medium. That makes 1 gallon of C. Paspali culture as alkaloid dense as 1 kilo of HBWR seeds... interested yet? Another interesting thing is that this fungus can be easily mutated and isolated to a form that will produce only LSA as opposed to the more complex alkaloids such as Ergometrine and Ergometrinine which are usually produced. This "alkaloid-blocked" mutant is easy to identify and much safer to culture. Sterilization of seed liquid cultures can be done fast and easy in quart jars in a domestic pressure cooker. 5-10 liters can be sterilzed in under an hour. Once these cultures are colonized, 5 liters could be used to easily innoculate a 15 gallon fermenter. The fermenter could include a heating element and PID controller to sterilize itself before innolcution. Many things in this process can be tweaked and through various tricks yields can be doubled no problem.
/end organization
Mutant isolation process: A high producing C. Paspali culture should be attained via academic routes (Easy peazy - if you are working in academia pm me).
There are a few methods posted on this thread but this is what I got from the above ref using UV.
Mycelium is cut from the culture and introduced to a sterile .9% NaCl solution in a tall, round, glass container with a stirbar and broken peices of glass. It is stirred until the mycelium is broken into fragments then hit with UV light (300J/M^2) for long enough to kill most of the cells. The mycelium is filtered and grown out across many sterile agar plates. The target mutant strain colonies will be visually different, only the mutant colonies will produce "honeydew" droplets. A few different "alkaloid-blocked" mutants are isolated and grown out on agar. Sterile liquid culture is prepared and innoculated with the various strains. Sterilized tubes from a highoutput filtered airpump and submerged into the liquid culture containers, filtered air exchange is made possible by a polyfill material filter. Once these containers have fermented long enough a sample is taken from each and productivity is tested via the Van Urke reagent. A qualitative test for ergo alkaloids might be good just to be on the safe side.
Once someone gets a stable mutant, send it to every crafty bee you can,
YOU can end LSD prohibition.
When looking up info for making your 50 gallon LSA fermenter, look up Claviceps purpurea. A lot more academic info about this one and growing conditions are similar.
Nutrient mixtures:
Many different nutrient mixtures in literature
Optimized for C. Paspali (from hyperlab russians)
150 g/l mannitol50 g/l peptone “Torlak” (Sabouraud dextrose agar ) in distilled water; pH was about 6.8 without regulation
Antibiotics can be added, if you can read through the hyperlab 'lsd from ergot' posts on WD there is good info in there.
Addition of sodium arsenate at levels between 1/50 - 1/20th the molar concentration of phosphate, 100% increase in yield - attached pdf
So to make it easy on you, boost phosphate to 2-5x normal levels, then add correct ratios of sodium arsenate
Starting culture:

Inoculation:

9 days later:

Under blacklight:

extraction.
Fermenter liquid is basified, large volume of non-polar is added and stirred. Non-polar is removed and ran through a silica filled tube to catch alkaloids. Tube is eluted and a small, concentrated volume of alkaloids remain. I believe this method was mentioned in otto snows books.
This is a rouge draft of a new post I was going to make... let me know what you guys think, open to criticism.
P.S. Jon: you mention adding diethylamine to the brew to produce LSD insitu, was this a misunderstanding? If not we need to go to any lengths to get that reference.